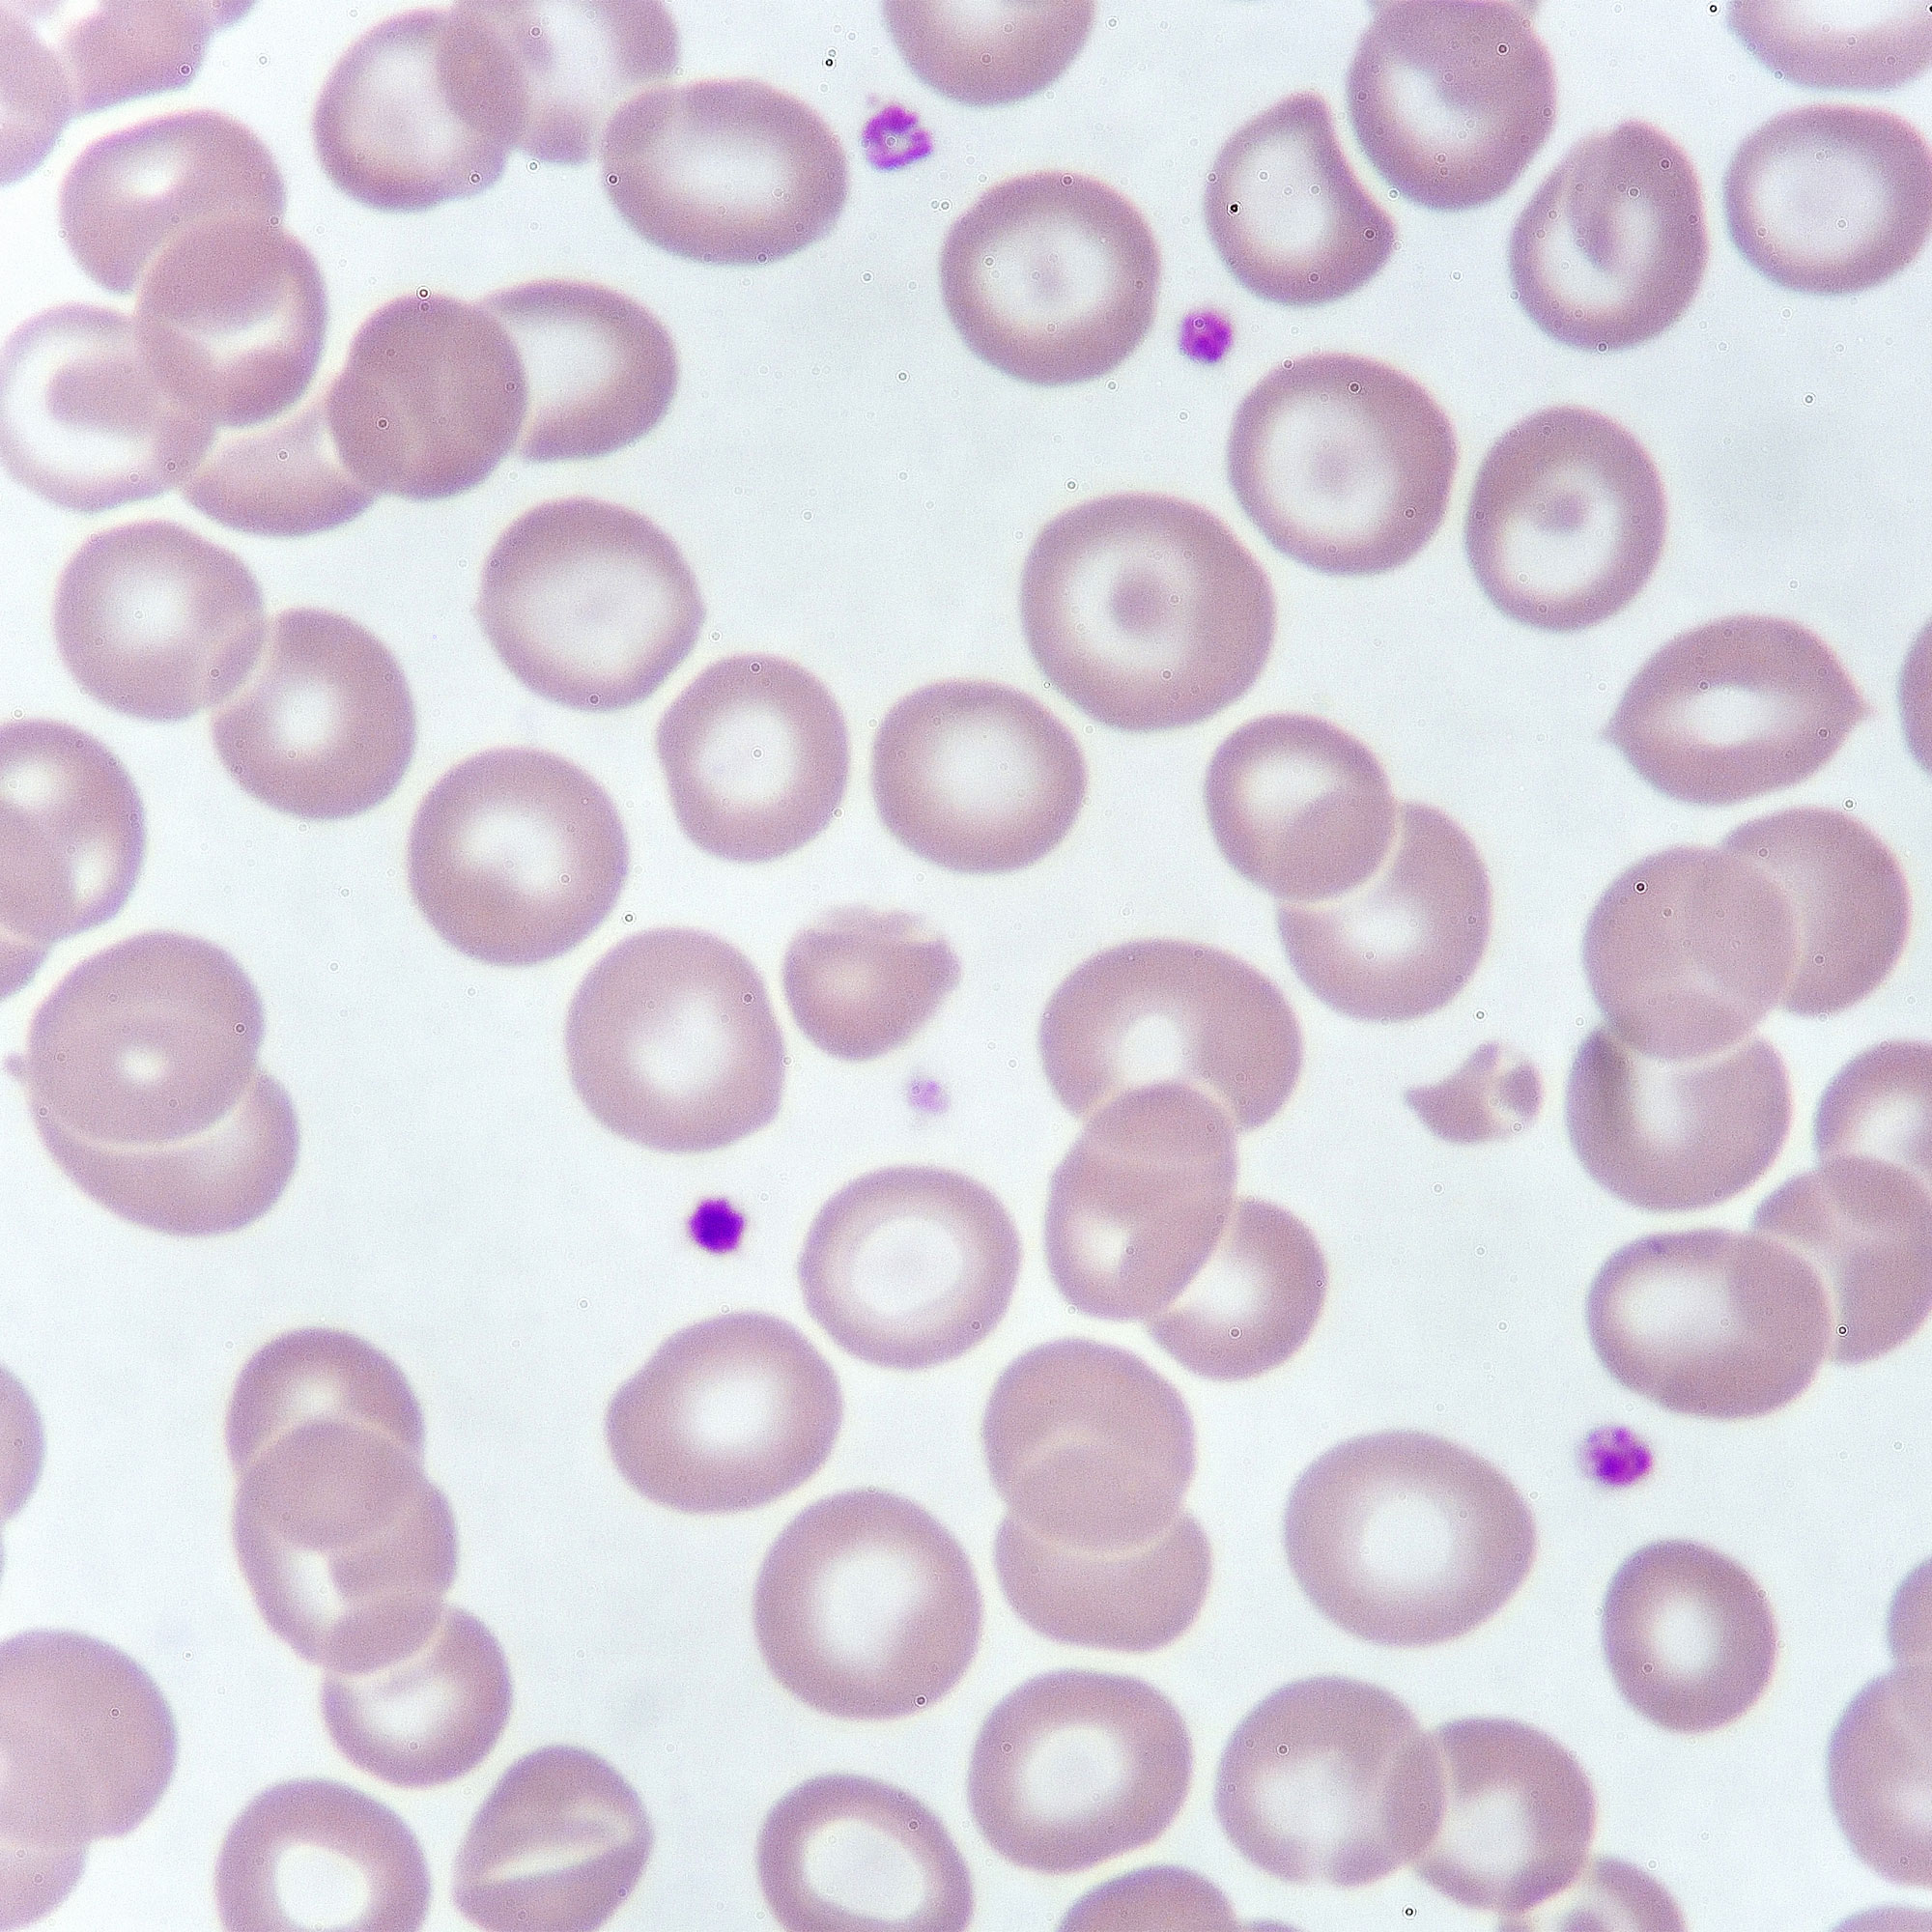
贫血病人红细胞的显微镜视图

转移性乳腺癌和贫血之间的联系是什么?
MBC的治疗,甚至是癌症本身,都可能导致帮助你对抗疾病的健康红细胞的产量下降。
为什么红细胞水平对MBC很重要?
你的红细胞执行着一项艰巨的任务:它们在全身输送氧气。但当它们减少时,“你可能会感到呼吸急促,或全身乏力,”位于加利福尼亚州圣莫尼卡的普罗维登斯圣约翰中心的乳腺外科肿瘤学家、玛吉·彼得森乳腺中心主任、医学博士珍妮·格鲁利解释说。其他症状包括头晕、虚弱、皮肤苍白、感觉寒冷或不宁腿综合征克利夫兰诊所.虽然在接受MBC治疗时很难区分症状,但格鲁利医生鼓励你如果怀疑贫血,就和肿瘤医生谈谈。
为什么转移性乳腺癌常见贫血?
贫血,又名低血红蛋白,在转移性乳腺癌中经常发生,因为癌症可能会影响到你的骨髓,或者,“最常见的是,贫血可能是用于治疗转移性癌症的治疗的副作用,”纽约市纽约大学朗格尼分校珀尔马特癌症中心专攻乳腺癌的医学肿瘤学家Yelena Novik博士解释说。这样anemia-triggering转移性乳腺癌的治疗通常包括化疗和放疗,诺维克博士补充道。
MBC和贫血的靶向治疗
“靶向疗法,或细胞周期抑制剂,会干扰红细胞的生长和成熟,”Novik博士说。治疗MBC的靶向疗法有多种,包括免疫疗法(增强免疫系统的疗法)。Novik博士解释说:“许多靶向药物在转移性乳腺癌的治疗中取得了巨大的成功,但它们会导致贫血。”和其他治疗一样,靶向治疗可能会影响骨髓,进而影响红细胞。一项研究表明,用于治疗MBC的药物恩赫图(fama -曲妥珠单抗- deruxtecan)仅导致8.7%的病例贫血新英格兰医学杂志.
转移性乳腺癌贫血的其他原因
Novik博士说:“除了用于治疗乳腺癌的药物的影响之外,MBC贫血还有其他可能的原因。”首先,“在一些涉及骨骼的乳腺癌病例中,癌细胞可以‘取代’健康的骨髓,导致新红细胞的产生减少,”她解释道。在极少数情况下,还可能导致贫血播散性血管内凝血病诺维克补充说,这是一种可能发生在乳腺癌中的凝血状态,会导致体内失血。特殊的实验室测试可以帮助确定这些医疗状况。
如何进行贫血筛查
两位专家都指出,你的癌症护理团队应该经常进行血液测试,以了解治疗进展情况,但如果你怀疑贫血,就说出来。为了进行筛查,医生会抽取少量血液,检查样本中的红细胞计数和血红蛋白水平。从那里,你的医生可以确定你贫血的原因,帮助确定你的治疗方法。Novik博士说:“由于贫血的原因可能非常不同,因此需要进行额外的检查以确定病因并纠正。”如果你被诊断为严重贫血,你的MBC治疗可能会改变,她补充说。
转移性乳腺癌治疗贫血
根据贫血的严重程度,在MBC治疗过程中有几种方法来处理贫血。格罗姆利医生说:“如果你的血液水平极低或有危险,或者你有症状”——意思是极度疲劳或无法正常工作——“我们会选择输血。”如果你的贫血不那么严重,你可能会被给予促进血细胞生长的药物。虽然补充铁是一种常见的贫血治疗方法,但没有证据表明它有助于增加MBS患者的红细胞克利夫兰诊所.
注意你的饮食来改善贫血症状
你可以通过吃来增加体内的铁元素,而且有很多铁元素含铁丰富的食物!对于那些对吃海鲜和肉类没有限制的人来说,以食物为基础的补铁选择包括肝香肠、金枪鱼、虾和红肉。根据最新的研究,素食友好的选择包括豆腐、鹰嘴豆、橙子、全谷物米饭、鸡油菌菇、燕麦片和甜菜。如果你是素食主义者,你可以多吃富含维生素c的食物,增加对铁的吸收.和你的医生谈谈你应该在你的盘子里添加多少这些食物来增加特定的铁水平。
监控mbbc相关性贫血是关键
“病人的护理转移性乳腺癌是一种360度全方位的护理,评估和解决贫血是这种方法的一部分,”诺维克博士说。当你正在接受MBC治疗时,某些疗法的副作用可能会让你精神上和身体上都感到痛苦,有时很难知道是治疗还是癌症引起了症状。所以,一定要向你的护理团队报告你的感觉,询问你的医生你的个人贫血风险,并了解为什么频繁抽血对监测你的健康是如此重要,因为你在与MBC战斗。
贫血的事实:梅奥诊所。“贫血。”(2022)。https://www.mayoclinic.org/diseases-conditions/anemia/diagnosis-treatment/drc-20351366
红细胞国家医学图书馆。“红细胞(RBC)计数”。https://medlineplus.gov/lab-tests/red-blood-cell-rbc-count/
贫血和转移性乳腺癌:克利夫兰诊所。“转移性乳腺癌和贫血之间的联系。”(2022)。https://health.clevelandclinic.org/anemia-and-metastatic-breast-cancer/
乳腺癌患者贫血发生率:药理学与药学进展“,.乳腺癌化疗患者贫血的患病率和相关因素:一项前瞻性研究。”(2022)。https://www.ncbi.nlm.nih.gov/pmc/articles/PMC9023199/
化疗和转移性乳腺癌:Dovepress.(2018.)“化疗诱导的贫血:病因学、病理生理学和对当代实践的影响。”https://www.dovepress.com/chemotherapy-induced-anemia-etiology-pathophysiology-and-implications--peer-reviewed-fulltext-article-IJCTM
弥散性血管内凝血与MBC:加拿大癌症协会。(无日期)。弥漫性血管内凝血https://cancer.ca/en/treatments/side-effects/disseminated-intravascular-coagulation
放疗与转移性乳腺癌(1):临床乳腺癌.“放疗前贫血在早期乳腺癌保乳治疗后局部复发和存活中的作用。”(2010)。https://pubmed.ncbi.nlm.nih.gov/20133262/
放疗与转移性乳腺癌(2):org:“转移性乳腺癌的放射治疗。”(2022)。https://www.breastcancer.org/treatment/radiation-therapy/radiation-for-metastatic
靶向药物治疗与转移性乳腺癌(1):美国癌症协会。“乳腺癌靶向药物治疗。”(2022)。https://www.cancer.org/cancer/breast-cancer/treatment/targeted-therapy-for-breast-cancer.html
靶向药物治疗与转移性乳腺癌(2):新英格兰医学杂志.曲妥珠单抗在既往治疗her2阳性乳腺癌中的应用。”(2019)。
https://pubmed.ncbi.nlm.nih.gov/31825192/
转移性乳腺癌和出血是贫血的一个原因:姑息医学年鉴.“癌症患者出血及其治疗:综述。”(2018)。https://apm.amegroups.com/article/view/17761/19368
转移性乳腺癌和弥散性血管内凝血:加拿大癌症协会。“弥散性血管内凝血。(无日期)。https://cancer.ca/en/treatments/side-effects/disseminated-intravascular-coagulation
铁食物来源:StatPearls.“膳食铁。”(2022)。https://www.ncbi.nlm.nih.gov/books/NBK540969/
维生素C和铁的吸收:澳大利亚医学杂志.“铁和素食。”(2014)。https://pubmed.ncbi.nlm.nih.gov/25369923/